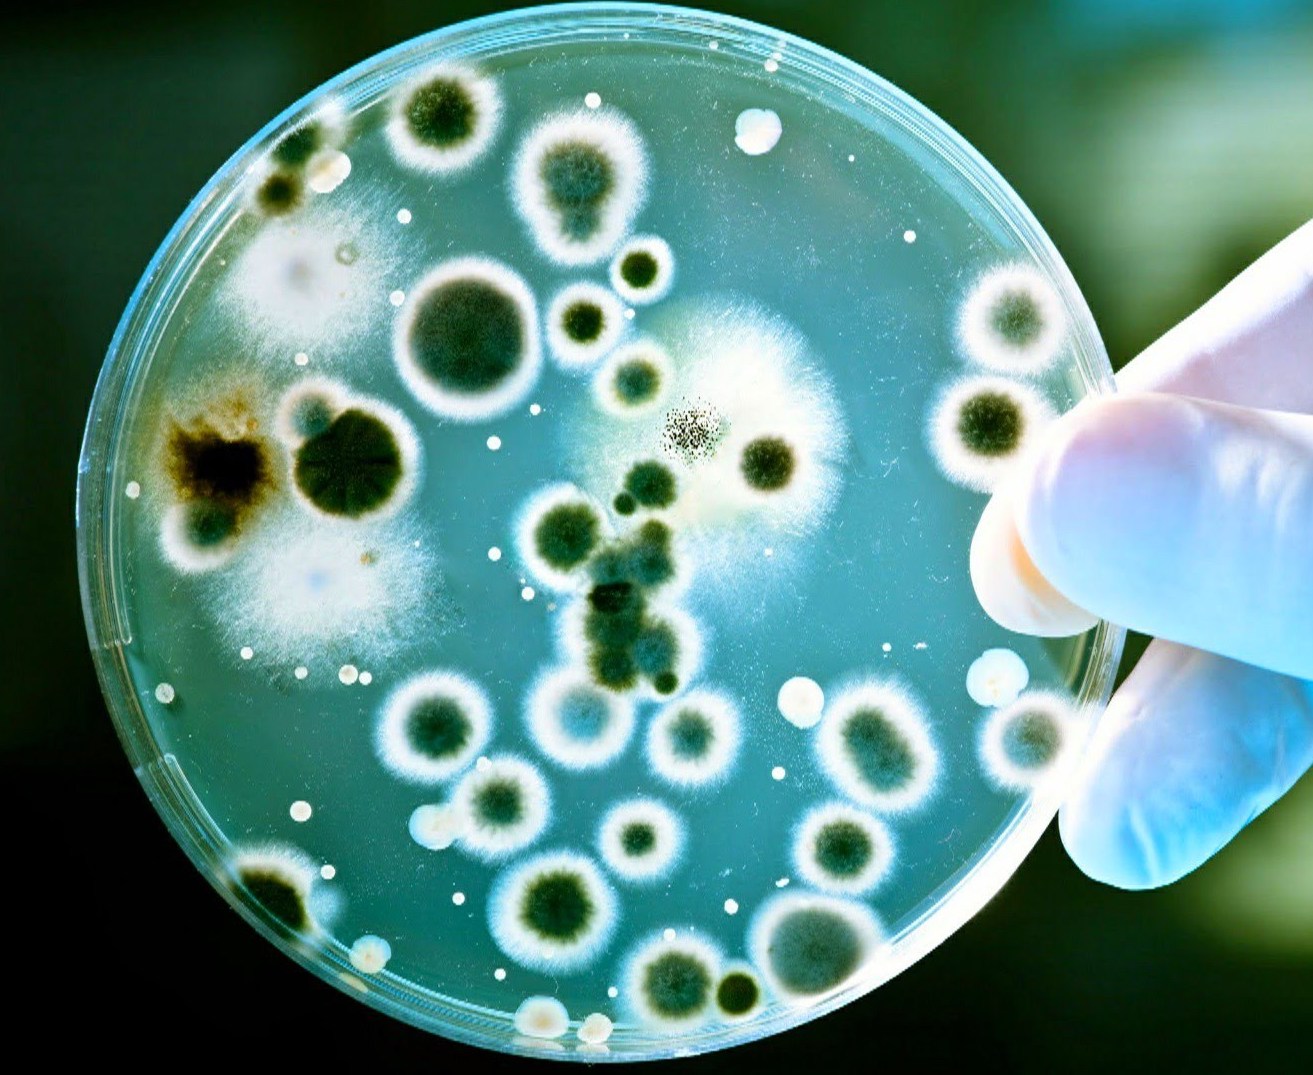

Программа базового очищения организма
«Метаболический детокс»
«Метаболический детокс»
За 21 день вы перезапустите организм на уровне клетки, очистите его от токсинов, шлаков и метаболических отходов. Повысите иммунитет, омолодите организм и укрепите свое здоровье.

Что лучше: профилактика или лечение?
Всего за 1 год в организм взрослого человека попадает в среднем 4л пестицидов, 5 кг продовольственных «улучшителей» вкуса, 2 кг токсичных веществ из воздуха. Эти яды накапливаются в костях, коже, волосах, в эритроцитах и лейкоцитах, в плазме крови.
Результат действия этих токсинов в нашем организме.

Быстрое старение.
Клетки, забитые токсинами, перестают обновляться и отмирают. Организм быстрее изнашивается и стареет.
Серьёзные заболевания.
Токсичные вещества снижают иммунитет, нарушают естественные функции организма, ведут к развитию серьёзных заболеваний, таких как заболевания сердечнососудистой системы, онкологические заболевания, заболевания центральной нервной системы (Альцгеймер, Паркинсон) и другие заболевания.
Быстрый набор веса.
Жировая ткань – биологическая ловушка для токсинов. Чем больше токсинов в организме, тем активней разрастается подкожно-жировая клетчатка и висцеральный жир. Это причина быстрого набора веса и ожирения внутренних органов.
Программа «Метаболический детокс» разработана с учётом женской физиологии, рассчитана на 21 день и проводится при индивидуальной ежедневной поддержке куратора-диетолога.
В течение 21 дня мы будем работать с главными органами детокс-системы организма – кишечником, лимфатической системой и печенью.
Как происходит настоящий детокс.
В организме есть главная очищающая магистраль: ЛИМФАТИЧЕСКАЯ СИСТЕМА-КИШЕЧНИК-ПЕЧЕНЬ,
именно на нее ложится вся нагрузка по выведению токсинов, клеточного мусора и шлаков из нашего организма.
именно на нее ложится вся нагрузка по выведению токсинов, клеточного мусора и шлаков из нашего организма.

А если с этими органами проблема? Лимфоток плохой и вся лимфатическая система забита! Кишечник плохо работает, активно множит внутри себя патогенные микроорганизмы! Печень страдает ожирением, перегружена токсинами и не может фильтровать кровь. При такой ситуации итог один -организм начинает болеть и активно стареть, так как токсины буквально разрушают его изнутри.
Помочь в этом случае организму детокс-соками и овощными диетами не получится. Это просто трата денег и времени. Нужно восстанавливать организм на уровне клетки (запускать процесс клеточного самоочищения), снижать загрязненность внутренней среды лимфатической системы и улучшать ее циркуляцию, разгружать лимфатические узлы от токсических веществ. Восстанавливать работу кишечника, очищать его от застойных каловых масс, и восстанавливать печень, улучшая ее фильтрующую функций.
Помочь в этом случае организму детокс-соками и овощными диетами не получится. Это просто трата денег и времени. Нужно восстанавливать организм на уровне клетки (запускать процесс клеточного самоочищения), снижать загрязненность внутренней среды лимфатической системы и улучшать ее циркуляцию, разгружать лимфатические узлы от токсических веществ. Восстанавливать работу кишечника, очищать его от застойных каловых масс, и восстанавливать печень, улучшая ее фильтрующую функций.

На программе вас ожидает:
Работа с кишечником:
1. Вы узнаете, откуда в вас берутся токсины, и определите степень интоксикации своего организма.
2. Вы начнете очищать кишечник от застойных каловых масс, продуктов гниения и патогенной микрофлоры.
3. Вы будете восстанавливать моторику и перистальтику кишечника, создадите условия для развития здорового микробиома.
4. Вам будет дано специальное ежедневное детокс-меню для очищения кишечника.
2. Вы начнете очищать кишечник от застойных каловых масс, продуктов гниения и патогенной микрофлоры.
3. Вы будете восстанавливать моторику и перистальтику кишечника, создадите условия для развития здорового микробиома.
4. Вам будет дано специальное ежедневное детокс-меню для очищения кишечника.
Работа с лимфатической системой:
1. Вы разберётесь с причинами интоксикации и застоя лимфы. Определите, в каком состоянии находится ваша лимфатическая система.
2. Освоите упражнения для разгона лимфы и техники лимфодренажа, стимулирующие очищение лимфатической системы.
3. Очистите лимфатическую систему и снизите токсическую нагрузку на лимфу.
4. Перейдёте на специальное меню для естественного очищения лимфы от токсинов.
2. Освоите упражнения для разгона лимфы и техники лимфодренажа, стимулирующие очищение лимфатической системы.
3. Очистите лимфатическую систему и снизите токсическую нагрузку на лимфу.
4. Перейдёте на специальное меню для естественного очищения лимфы от токсинов.
Работа с печенью и клетками:
1. Вы запустите механизм самоочищения клетки от токсинов и метаболических отходов методом аутофагии.
2. Вы снимите токсическую нагрузку с печени, улучшите фильтрующую функцию печеночных клеток.
3. Вы начнём восстанавливать клетки печени гепатоциты и снижать жировую нагрузку на клетки печени.
4. Вы получите меню на каждый день для восстановления функций печени и обновления её клеток.
2. Вы снимите токсическую нагрузку с печени, улучшите фильтрующую функцию печеночных клеток.
3. Вы начнём восстанавливать клетки печени гепатоциты и снижать жировую нагрузку на клетки печени.
4. Вы получите меню на каждый день для восстановления функций печени и обновления её клеток.
Детокс Мозга:
1. Вы проработаете негативные и патологические способы мышления, которые ведут к стрессам, негативным эмоциям и саморазрушению организма.
2. Подключите исцеляющие ресурсы мозга, и запустите механизм самоисцеления тела.
3. Познакомитесь с феноменом нейропластичности мозга.
4. Избавитесь от пагубных привычек, которые разрушают ваше счастье и здоровье.
2. Подключите исцеляющие ресурсы мозга, и запустите механизм самоисцеления тела.
3. Познакомитесь с феноменом нейропластичности мозга.
4. Избавитесь от пагубных привычек, которые разрушают ваше счастье и здоровье.
Что вас ждет в программе "Метаболический детокс"
1
Специально разработанное меню для очищения лимфатической системы и снижения токсической нагрузки.
2
Специально разработанное меню для улучшения кишечной микрофлоры, избавления от патогенов и улучшения моторики.
3
Специально разработанное меню для снижения токсической нагрузки на печень и улучшения работы клеток печени-гепатоцитов.
4
Доступ в личный кабинет к еженедельным видеоуроками и методическими материалами.
5
Доступ к диетологу-куратору в личном кабинете для коррекции программы и консультаций.
6
Еженедельные вебинары с куратором-диетологом, они также буду даваться в записи.
7
Вебинары с руководителем центра похудения Кристины Шереметьевой по подключению ресурсов мозга и самоисцеления тела.
8
Освоение техник когнитивно-поведенческой психотерапии, проработки скрытых бессознательных причин болезней тела и преждевременного разрушения организма.
9
Специальный комплекс упражнений для профилактики отёков, варикоза и застойных явлений.
10
Лимфодренажные техники для улучшения лимфотока и уменьшения целлюлита.
11
Авторские методики для улучшения работы кишечника, его опорожнения и моторики.
12
Рецепты детокс-коктейлей и фитонастоев.
13
Гиды по продуктам и бытовым токсинам.
14
Методическое пособие по нутриентам, необходимых для корректной детоксикации организма.

Всего за 21 день программы вы добьётесь отличных результатов:
Перезапустите организм на уровне клетки.
Затормозите процессы старения.
Запустите самоисцеляющие силы организма, которые надолго сохранят ваше здоровье и молодость.
Снизите общую токсическую нагрузку на организм и укрепите иммунитет.
Улучшите состояние лимфатической системы: избавитесь от отёков, целлюлита, повышенной утомляемости.
Улучшите работу кишечника, начнёте избавляться от запоров, метеоризмов и вздутий, очистите его от токсинов.
Улучшите фильтрующую функцию печени.
Очистите жировую ткань от токсинов и подготовитесь к активному похудению.
Стоимость программы:
Обычная цена 8900 рублей
Цена со скидкой 5900 рублей
Обычная цена 8900 рублей
Цена со скидкой 5900 рублей
До поднятия цен осталось:
Дней
Часов
Минут
Секунд